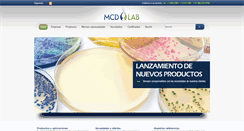
Desktop Preview
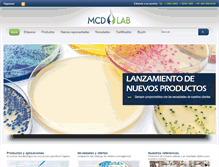
Tablet Preview

MCDLAB.NET
MCD LaboratoriosEstamos a su servicio. Tel.: 5384-2095 5319-7308 01 800 838-9788. El control microbiológico es crucial para garantizar higiene. Los productos MCD LAB son fabricados cumpliendo estrictas normas y especificaciones. Los proveedores de insumos han sido seleccionados para contar con las materias primas de la más alta calidad y confiabilidad. Ampliación del catálogo de medios cromogénicos. Productos de máxima calidad y un resultado óptimo para nuestros clientes. Consulta nuestros certificados ISO.
http://www.mcdlab.net/